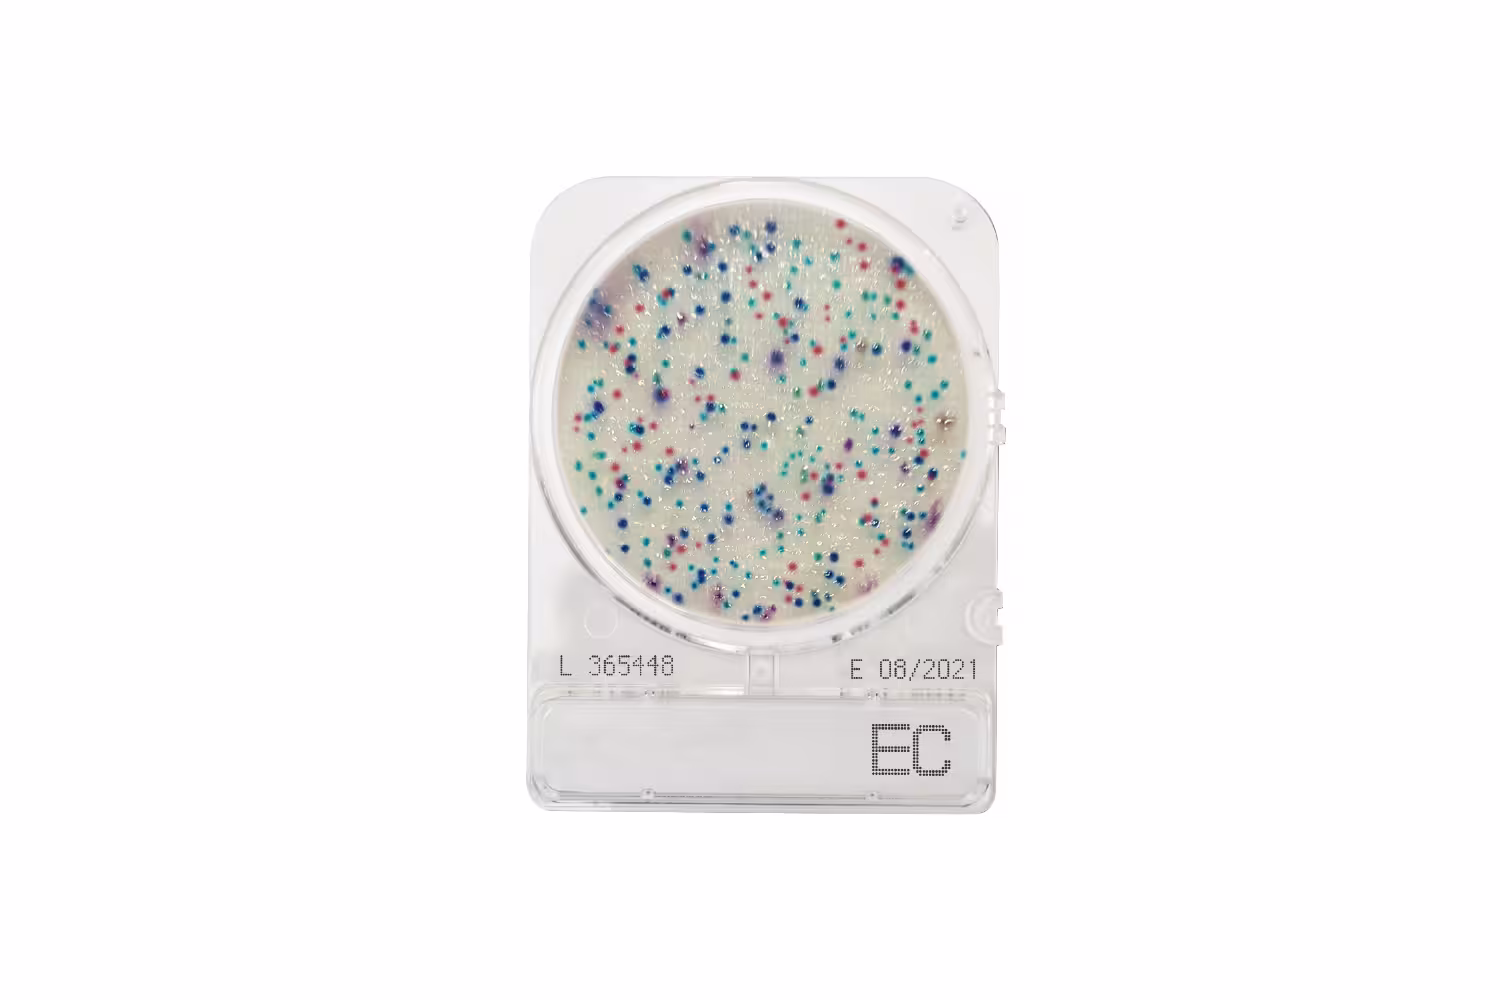

- Home
- About Us
-
Products
- Sectors
- All Categories
- Animal Blood, Serum & Plasma
- Animal Blood, Serum & Plasma
- Cell Culture Reagents & Supplements
- Cell Culture Reagents & Supplements
- Clinical Solutions
- Clinical Solutions
- Food, Beverage & Industrial Microbiology
- Food, Beverage & Industrial Microbiology
- Human Biospecimens
- Human Biospecimens
- QC Organisms & Controls
- QC Organisms & Controls
- Water & Environmental
- Water & Environmental
- Products and Information categorised by Product Type
- Algal Toxin Detection
- Product Categories:
- Algal Toxin Detection
- Product Information Page:
- Algal Toxin Detection
- Animal Blood Products
- Product Categories:
- Chicken Blood Cells (Adult) in Alsever's
- Donor Horse Blood
- Donor Sheep Blood
- Guinea Pig Blood Cells in Alsever's
- Rabbit Blood
- Product Information Page:
- Donor Animal Blood
- Animal Free Recombinant Proteins
- Product Categories:
- Animal Free Recombinant Proteins
- Product Information Page:
- Recombinant Proteins
- Animal Serum and Plasma
- Bacteria and Biofilm Detection Systems
- Product Categories:
- Bacteria and Biofilm Detection Systems
- Product Information Page:
- Bacteria and Biofilm Detection Systems
- Biospecimens
- Product Categories:
- Body Fluids
- Human Biomarkers
- Placentas
- Product Information Page:
- Human Biospecimens
- Cryptosporidium and Giardia
- Product Categories:
- Enumerated Quality Control Products Cryptosporidium / Giardia
- Fluorescent Conjugated antibodies Cryptosporidium / Giardia
- Immunomagnetic Separation
- Inactive Bulk Cryptosporidium oocysts and Giardia cysts
- Product Information Pages:
- ColorSeed™
- EasySeed™
- EasyStain™
- Oocysts and Cysts
- Diagnostic Kits
- Product Categories:
- Kits & Controls
- Dyes and Stains
- Product Categories:
- Dry Dyes and Stains
- Stain Concentrates
- Stain Packs
- Wet Dyes and Stains
- Product Information Page:
- Dyes and Stains
- ECM Proteins
- Product Categories:
- ECM Proteins
- Product Information Pages:
- Cytocaf Technologies
- GelEnhance-Cytocaf
- LamininB4-Cytocaf
- Fibronectin-Cytocaf
- Vitronectin-Cytocaf
- Gonorrhoea and Streptococcus Detection
- Product Categories:
- Gonorrhoea and Streptococcus Detection
- Product Information Page:
- Gonochek®-II for Neisseria spp
- Histology
- Product Categories:
- Buffers and Solutions
- Dry Dyes and Stains
- Embedding and Mounting Media
- Stain Packs
- Wet Dyes and Stains
- Product Information Page:
- Dyes and Stains
- Human Plasma
- Product Categories:
- Human Plasma
- Product Information Page:
- Human Serum and Plasma
- Human Platelet Lysate (HPL)
- Product Categories:
- Fibrinogen-Depleted and Gamma-Irradiated HPL Products
- Fibrinogen-Depleted HPL Products
- Standard HPL Products
- Product Information Page:
- Human Platelet Lysate (HPL)
- Human Serum
- Product Categories:
- Human Serum
- Product Information Page:
- Human Serum and Plasma
- Human Serum and Plasma Disease State
- Product Categories:
- Human Serum and Plasma Disease State
- Product Information Page:
- Human Serum and Plasma (Disease State Profiles)
- Hydrogels
- Product Categories:
- Hydrogels
- Product Information Page:
- Fully Defined Hydrogels
- Laboratory Equipment & Consumables
- Microbiological Media
- Product Categories:
- Bacticount Dipslides
- Compact Dry™ Chromogenic Media Plates
- Product Information Pages:
- Bacticount Slides
- Compact Dry™
- Microbiological Quality Control Organisms
- Product Categories:
- Accu-Bac Quantitative Micro-organisms
- Selectrol® Qualitative Micro-organisms
- Product Information Pages:
- Accu-Bac Quantitative Micro-Organisms
- Selectrol® Qualitative Micro-organisms
- Microcarriers
- Product Categories:
- Microcarriers
- Product Information Page:
- Microcarriers
- Microfluidics
- Product Categories:
- Microfluidics
- Product Information Page:
- Microfluidic Solutions
- Non-Adherent Reagents
- Product Categories:
- AntiClump-Cytocaf
- LowAdhere-Cytocaf
- Product Information Pages:
- Cytocaf Technologies
- Anticlump-Cytocaf
- LowAdhere-Cytocaf
- Algal Toxin Detection
- Services
- Quality Certificates
- Resources
- News
- Contact